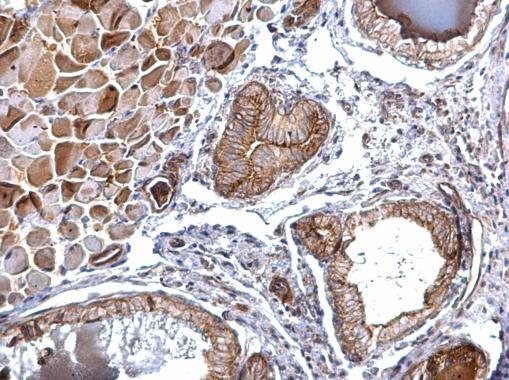
FOLR2 Antibody in Immunohistochemistry (Paraffin) (IHC (P))

Search
Invitrogen
FOLR2 Polyclonal Antibody
{{$productOrderCtrl.translations['antibody.pdp.commerceCard.promotion.promotions']}}
{{$productOrderCtrl.translations['antibody.pdp.commerceCard.promotion.viewpromo']}}
{{$productOrderCtrl.translations['antibody.pdp.commerceCard.promotion.promocode']}}: {{promo.promoCode}} {{promo.promoTitle}} {{promo.promoDescription}}. {{$productOrderCtrl.translations['antibody.pdp.commerceCard.promotion.learnmore']}}
图: 1 / 2
FOLR2 Antibody (PA5-77980) in IHC (P)


产品信息
PA5-77980
种属反应
宿主/亚型
分类
类型
抗原
偶联物
形式
浓度
规格
纯化类型
保存液
内含物
保存条件
运输条件
RRID
产品详细信息
Positive Control: Jurkat, Raji, NCI-H929
Predicted Reactivity: Rat (84%), Rhesus Monkey (97%), Bovine (86%)
Store product as a concentrated solution. Centrifuge briefly prior to opening the vial.
靶标信息
FOLR2 is a member of the folate receptor (FOLR) family, and these genes exist in a cluster on chromosome 11. Members of this gene family have a high affinity for folic acid and for several reduced folic acid derivatives, and they mediate delivery of 5-methyltetrahydrofolate to the interior of cells. This protein has a 68% and 79% sequence homology with the FOLR1 and FOLR3 proteins, respectively. Although this protein was originally thought to be specific to placenta, it can also exist in other tissues, and it may play a role in the transport of methotrexate in synovial macrophages in rheumatoid arthritis patients.
仅用于科研。不用于诊断过程。未经明确授权不得转售。
篇参考文献 (0)
生物信息学
蛋白别名: FBP; folate binding protein 2; Folate receptor 2; folate receptor 2 (fetal); folate receptor alpha; Folate receptor beta; Folate receptor, fetal/placental; Folate-binding protein 2; folate-binding protein, fetal/placental; FR-beta; Placental folate-binding protein
基因别名: BETA-HFR; FBP; FBP/PL-1; FBP2; Folbp-2; Folbp2; FOLR1; FOLR2; FR-BETA; FR-P3; FRbeta
UniProt ID: (Human) P14207, (Mouse) Q05685
Entrez Gene ID: (Human) 2350, (Mouse) 14276